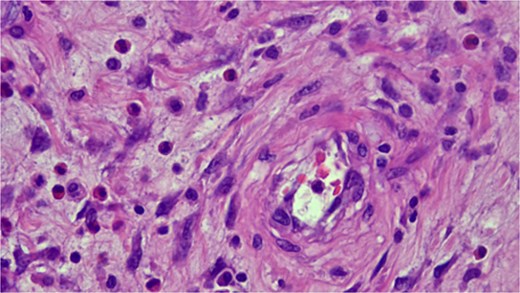
Histopathologic examination showing spindle cells in a fibromyxoid stroma with a mixed inflammatory reaction, consistent with an IFP (Vanek’s tumor).

-
PDF
- Split View
-
Views
-
Cite
Cite
Islam Rajab, Ahmad Nouri, Hala Mousa, Nuha Riyad, Mohamed Elagami, Walid Baddoura, Ileo-ileal intussusception due to Vanek’s tumor: a rare cause of small bowel obstruction, Journal of Surgical Case Reports, Volume 2025, Issue 6, June 2025, rjaf383, https://doi.org/10.1093/jscr/rjaf383
Close - Share Icon Share
Abstract
Inflammatory fibroid polyps (IFPs), also known as Vanek’s tumors, are rare, benign mesenchymal neoplasms of the gastrointestinal tract, most commonly found in the gastric antrum. However, small bowel involvement is exceedingly uncommon, and when present, it can lead to intussusception, a rare yet serious complication. Here, we report a case of a 65-year-old female with a history of diabetes mellitus, hypertension, and dyslipidemia who presented with persistent abdominal pain and gastrointestinal symptoms. Imaging revealed an ileo-ileal intussusception, necessitating surgical resection. Histopathology confirmed an IFP as the lead point. This case highlights the diagnostic and therapeutic challenges of IFPs in the small intestine and underscores the importance of considering rare causes of intussusception in adults.
Introduction
Inflammatory fibroid polyps (IFPs), also known as Vanek’s tumors, are rare, benign lesions originating from the submucosa of the gastrointestinal tract. First described by Vanek in 1949 [1], IFPs are classified as connective tissue tumors and can affect both sexes, though they are slightly more common in men. Typically, they occur in the gastric antrum and account for ~0.1% of all gastric polyps [2]. While primarily affecting the stomach, IFPs can rarely involve the small intestine and colon, occasionally causing complications like bowel obstruction, presenting as intussusception [3].
In this report, we present a unique case of an ileal IFP causing intussusception, an infrequent yet clinically significant manifestation of this benign lesion. Our case underscores the diagnostic challenges and highlights the need for surgical intervention in symptomatic patients.
Clinical presentation
The patient, a 65-year-old female with a medical history significant for diabetes mellitus with neuropathy, hypertension, dyslipidemia, obstructive sleep apnea, vitamin D deficiency, and fatty liver disease, had been managing multiple chronic conditions when she began experiencing troubling symptoms. Her past surgical history included a cholecystectomy and a normal colonoscopy in 2021, performed for a positive fecal occult blood test. She had no family history of colon cancer and had generally stable health until her recent complaints.
She initially presented with persistent abdominal pain localized to the epigastric and suprapubic regions, radiating to her back. The pain was accompanied by nausea without vomiting, bloating, and reflux symptoms, which were exacerbated by spicy and fatty foods. At times, she reported diarrhea that was non-bloody and non-black, though constipation was a later symptom. Despite treatment with proton pump inhibitors, her symptoms persisted, prompting further evaluation.
Imaging revealed an ileo-ileal intussusception with mild fat stranding but no evidence of bowel obstruction. This finding led to an ileal resection (17 cm) with primary anastomosis and lysis of adhesions. Pathology from the resected segment identified a benign spindle cell lesion consistent with an IFP, also known as Vanek’s tumor (Fig. 1).
Histopathologic examination showing spindle cells in a fibromyxoid stroma with a mixed inflammatory reaction, consistent with an IFP (Vanek’s tumor).
The patient recovered well postoperatively, with complete resolution of symptoms. At follow-up, there was no evidence of recurrence, reaffirming the benign nature of the lesion and the efficacy of surgical resection as a definitive treatment.
Discussion
IFPs are rare, benign polyps of the gastrointestinal tract [4]. The condition was first described in 1949 [1], with six cases initially identified as submucosal granulomas of the stomach featuring eosinophilic infiltration. Over time, these lesions were referred to by various names, including inflammatory pseudotumor, eosinophilic granuloma, and polyp with eosinophilic granuloma [5]. In 1953, Helwig and Ranier officially introduced the term “inflammatory fibroid polyp” (IFP) to categorize the disease more precisely [6].
IFPs were historically considered reactive inflammatory lesions, potentially linked to Helicobacter infection or gastritis [7]. However, the discovery of PDGFRA mutations in IFPs revealed their neoplastic nature. The exact cause remains unclear, though factors like trauma, allergic reactions, genetic predisposition, and bacterial or chemical stimuli have been proposed. Some suggest that chronic irritation, intestinal trauma, or a localized form of eosinophilic gastroenteritis might trigger the development of these polyps due to their significant eosinophilic infiltration [8].
IFPs are often asymptomatic and remain undetected until found incidentally during endoscopy or surgery. When symptoms do occur, they depend on the polyp's location and size. In the stomach, abdominal pain is common, while intussusception and bowel obstruction occur when IFPs are located in the small intestine. Less frequent symptoms include vomiting, diarrhea, and bloody stools. In rare cases, IFPs can cause severe complications like necrosis or perforation [2].
The sensitivities of various radiological methods for diagnosing intestinal intussusceptions show significant variability. Ultrasound is the preferred imaging technique, offering a sensitivity of 98%–100%, a specificity of 88%, and a negative predictive value of 100%. Computed tomography (CT) scans, particularly for surgical enteroenteric lesions over 3.5 cm in length, demonstrate 100% sensitivity, but only 57.3% specificity. Similarly, polyps larger than 3 cm in axial diameter have a sensitivity of 100%, but the specificity is much lower, at 32.9%. Both methods, however, show high negative predictive values [9]. Magnetic resonance imaging (MRI) can assist in diagnosing intussusception by displaying the characteristic "bowel-within-bowel" or "coiled-spring" appearance. A polyp can be identified as a leading cause using T2-weighted MRI and gadolinium-enhanced T1-weighted imaging. In a study comparing MRI and CT, MRI was more effective in diagnosing intestinal obstruction, correctly identifying the cause in 95% of cases, compared to 71% for CT. MRI showed a sensitivity, specificity, and accuracy of 95%, 100%, and 96%, respectively, while CT had 71% for all three measures [2].
The diagnosis and treatment of gastric IFPs can be achieved through gastroscopy [10]. Double-balloon enteroscopy, or “push-and-pull” enteroscopy, enables the examination of 70–150 cm of the small intestine and allows for complete small bowel examination in both antegrade and retrograde directions [11]. Capsule endoscopy, a noninvasive test, helps identify sources of gastrointestinal bleeding, intussusception, and tumors. Colonoscopy is useful when colonic involvement is suspected, allowing for diagnosis and biopsy. However, intussusception is rarely diagnosed through colonoscopy and is usually detected during surgery [12, 13].
Several differential diagnoses must be considered when diagnosing IFPS. Adenomatous polyps are the most common benign lesions, typically small in size. Intestinal lipomas are characterized by the presence of fat on CT and MRI. Lymphomas, representing 20%–40% of malignant small bowel lesions, appear as large endoluminal tumors. Gastrointestinal stromal tumors (GISTs) have a similar appearance to IFPs but typically exhibit partial extraluminal growth, irregular margins, and a heterogeneous texture. These features help differentiate IFPs from other lesions [14].
During an endoscopic examination, IFPs can appear as either sessile or pedunculated, often exhibiting superficial erosion or ulceration. It is important to differentiate IFPs from GISTs, which make up 1% of all gastrointestinal tumors. Immunohistochemistry can aid in distinguishing between the two, as both IFPs and GISTs express CD34, GISTs are more commonly to be positive for CD117 (c-kit). Additionally, IFPs are associated with mutations in exon 12 of the PDGFRA gene [15].
Microscopically, IFPs are composed of spindle-shaped, mononuclear cells arranged in a whorled or "onion skin" pattern around blood vessels and glands. The inflammatory infiltrate includes eosinophils, lymphocytes, macrophages, mast cells, and blood vessels, with a matrix of fine or collagen-rich fibrils. The classic gastric type, rich in eosinophils, has many spindle cells but minimal collagen, while the intestinal type is less cellular and more collagen-rich [16].
Exploratory laparotomy is commonly advised as the preferred treatment for intussusception caused by IFPs. These polyps generally lack malignant potential, and reports of recurrence after removal are extremely rare [13].
Conclusion
IFPs, while benign, can present with significant clinical complications such as intussusception, necessitating prompt diagnosis and surgical management. This case highlights the importance of considering IFPs in the differential diagnosis of small bowel obstruction, particularly in adults. Awareness of their characteristic histopathological features can aid in accurate diagnosis and appropriate intervention. Surgical resection remains the definitive treatment, with an excellent prognosis and low recurrence risk.
Conflict of interest statement
On behalf of all authors, the corresponding author states that there is no conflict of interest.
Funding
No funding was received to assist with the preparation of this manuscript.
Data availability
Data sharing is not applicable to this article as no datasets were generated or analyzed during the current study.
Informed consent to participate
Written informed consent was obtained from the patient herself. The participant has consented to the submission of the case report to the journal.
Ethical approval
Our institution does not require ethical approval for reporting individual cases or case series.